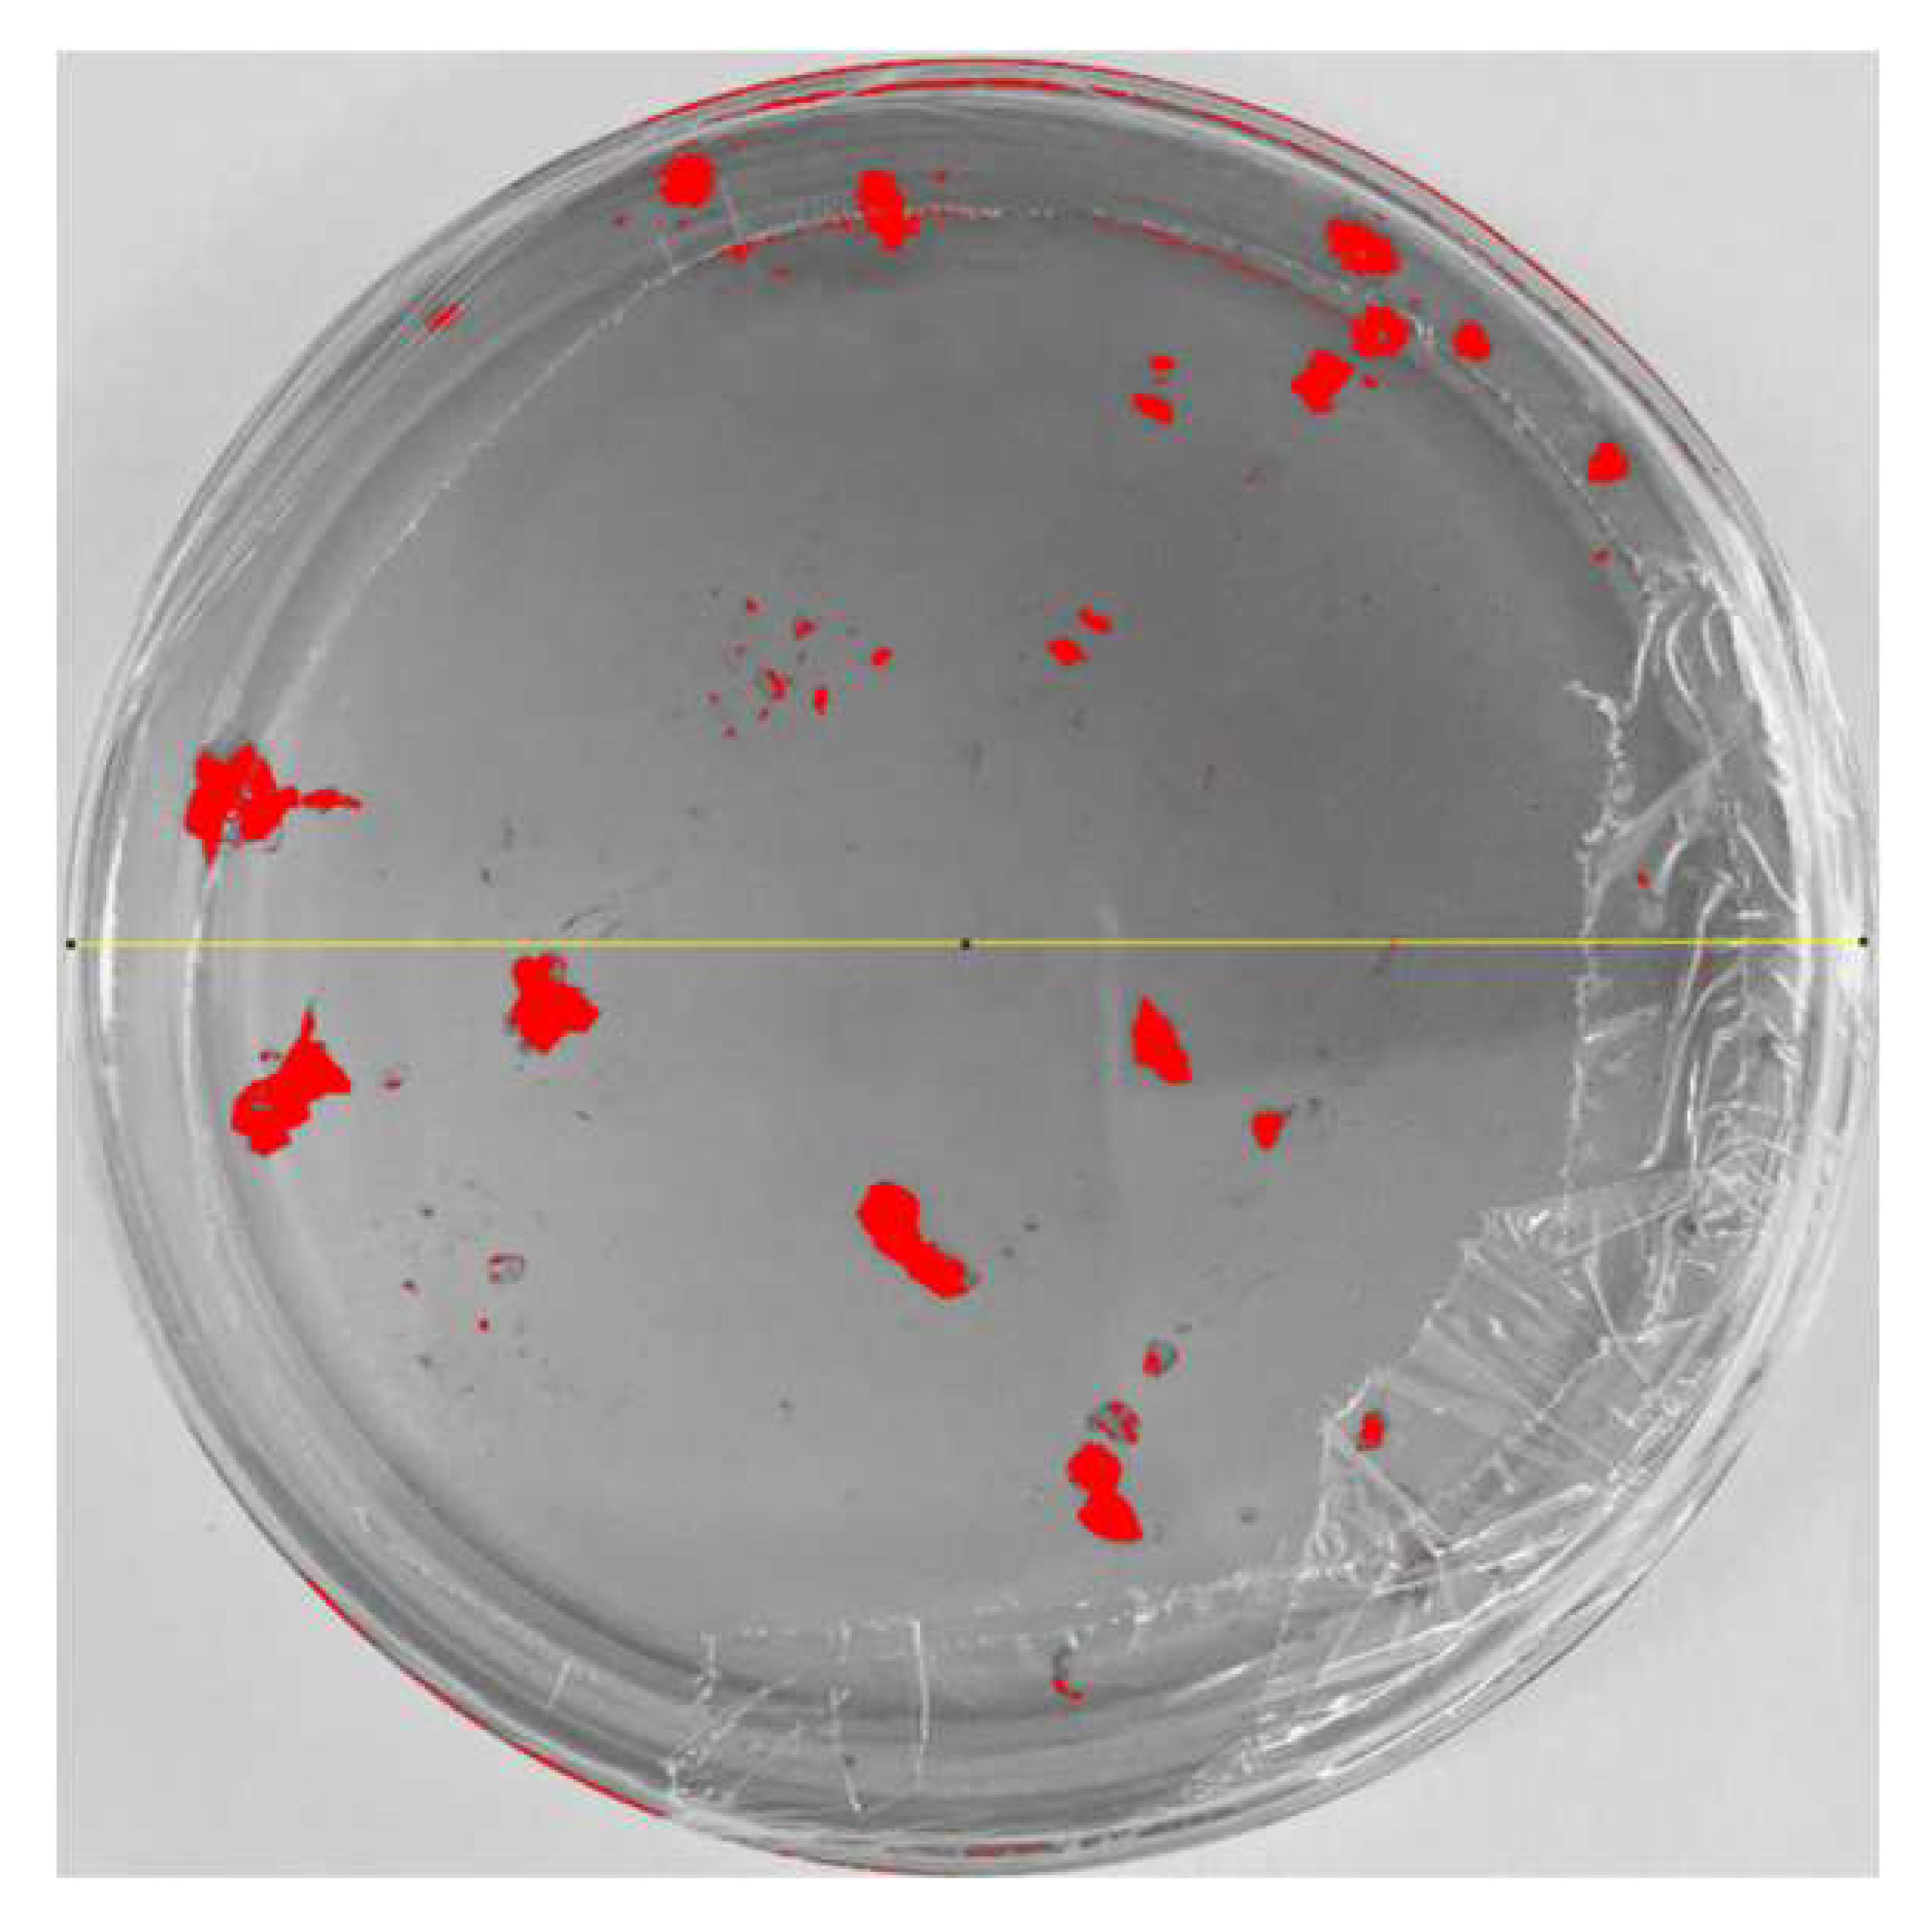
Nanomaterials 15 00379 i005
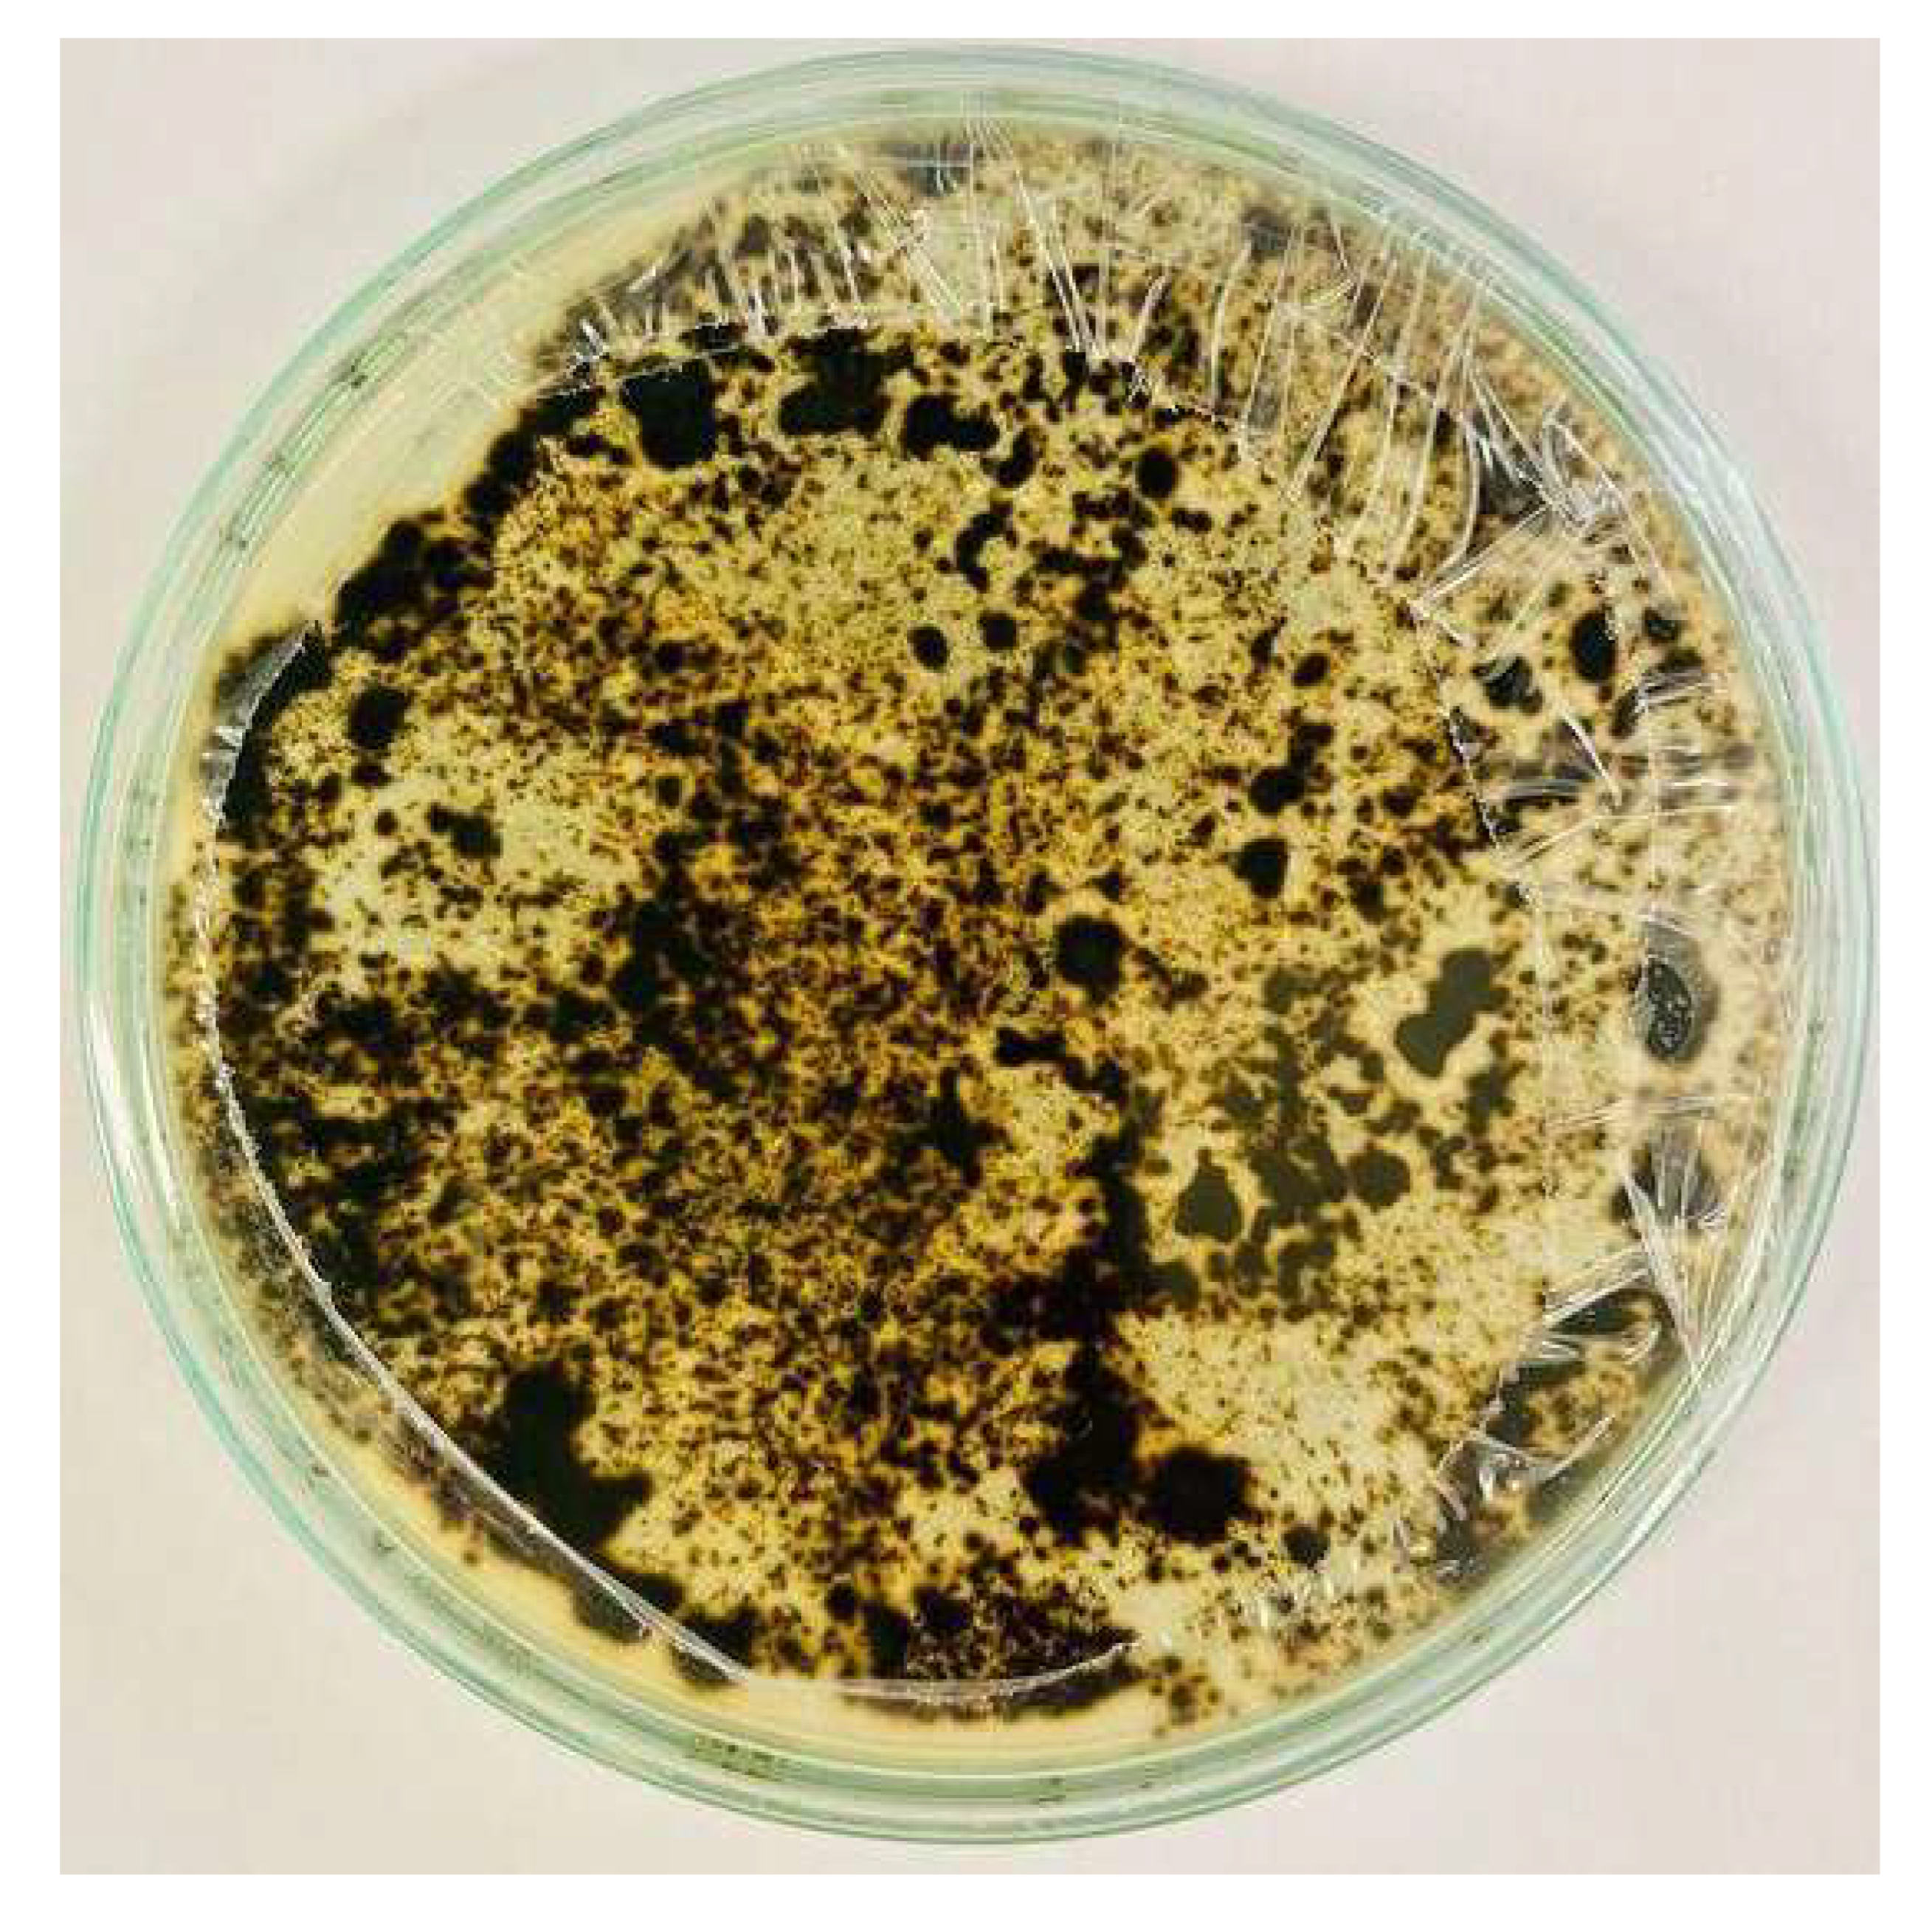
Nanomaterials 15 00379 i007

Metal Nanoparticles Obtained by Green Hydrothermal and Solvothermal Synthesis: Characterization, Biopolymer Incorporation, and Antifungal Evaluation Against Pseudocercospora fijiensis
Abstract
1. Introduction
2. Materials and Methods
2.1. Materials
2.2. Preparation of Medicago Sativa Extract
2.3. Synthesis of NPs
2.4. Characterization of NPs
2.5. Bioassays
2.6. CS-NP Nanocomposite
3. Results and Discussion
3.1. Characterization of Medicago Sativa Extract
3.2. Characterization of NPs
3.3. Determination of Point of Zero Charge
3.4. Morphological and Structural Analysis
3.5. FTIR Analysis
3.6. Characterization of CS/Metal NP Nanocomposite by AFM
3.7. SEM Characterization (CS/Metal NP Nanocomposites)
3.8. Efficiency of Antifungal or Inhibitory Action
3.9. Bioassays with NPs (Solvothermal)
3.10. Bioassays with NPs (Green Hydrothermal)
4. Conclusions
Author Contributions
Funding
Data Availability Statement
Acknowledgments
Conflicts of Interest
Abbreviations
| NPs | nanoparticles |
| CS | chitosan |
| UV–vis | UV–visible spectroscopy |
| FTIR | Fourier-transform infrared spectroscopy |
| AFM | atomic force microscopy |
| SEM | scanning electron microscope |
| EDS | energy dispersive spectrometry |
| FE-SEM | field emission scanning electron microscopy |
| PDA | potato dextrose agar |
| PZC | point of zero charge |
| pHpzc | pH of the point of zero charge |
| NCHR | non-contact/high-resonance frequency reflex coating |
References
- Labanni, A.; Nasir, M.; Arief, S. Research progress and prospect of copper oxide nanoparticles with controllable nanostructure, morphology, and function via green synthesis. Mater. Today Sustain. 2023, 24, 100526. [Google Scholar] [CrossRef]
- Kaningini, A.G.; Nelwamondo, A.M.; Azizi, S.; Maaza, M.; Mohale, K.C. Metal Nanoparticles in Agriculture: A Review of Possible Use. Coatings 2022, 12, 1586. [Google Scholar] [CrossRef]
- Tomar, R.; Abdala, A.A.; Chaudhary, R.; Singh, N. Photocatalytic degradation of dyes by nanomaterials. Mater. Today Proc. 2020, 29, 967–973. [Google Scholar] [CrossRef]
- Roduner, E. Size matters: Why nanomaterials are different. Chem. Soc. Rev. 2006, 35, 583–592. [Google Scholar] [CrossRef]
- Asha, A.B.; Narain, R. Chapter 15—Nanomaterials properties. In Polymer Science and Nanotechnology; Na-rain, R., Ed.; Elsevier: Amsterdam, The Netherlands, 2020; pp. 343–359. [Google Scholar] [CrossRef]
- Krishnan, S.K.; Singh, E.; Singh, P.; Meyyappan, M.; Singh Nalwa, H. A review on graphene-based nanocomposites for electrochemical and fluorescent biosensors. RSC Adv. 2019, 9, 8778–8881. [Google Scholar] [CrossRef] [PubMed]
- Mittal, A.K.; Banerjee, U.C. Chapter 5—Current status and future prospects of nanobiomaterials in drug delivery. In Nanobiomaterials in Drug Delivery; Grumezescu, A.M., Ed.; William Andrew Publishing: Norwich, NY, USA, 2016; pp. 147–170. [Google Scholar] [CrossRef]
- Wu, Q.; Miao, W.-S.; Zhang, Y.-D.; Gao, H.-J.; Hui, D. Mechanical properties of nanomaterials: A review. Nanotechnol. Rev. 2020, 9, 259–273. [Google Scholar] [CrossRef]
- Vijayaprasath, G.; Murugan, R.; Mahalingam, T.; Ravi, G. Comparative study of structural and magnetic properties of transition metal (Co, Ni) doped ZnO nanoparticles. J. Mater. Sci. Mater. Electron. 2015, 26, 7205–7213. [Google Scholar] [CrossRef]
- Cruz-Luna, A.R.; Cruz-Martínez, H.; Vásquez-López, A.; Medina, D.I. Metal Nanoparticles as Novel Antifungal Agents for Sustainable Agriculture: Current Advances and Future Directions. J. Fungi 2021, 7, 1033. [Google Scholar] [CrossRef]
- Issa, B.; Obaidat, I.M.; Albiss, B.A.; Haik, Y. Magnetic nanoparticles: Surface effects and properties related to biomedicine applications. Int. J. Mol. Sci. 2013, 14, 21266–21305. [Google Scholar] [CrossRef]
- Babu, G.A.; Ravi, G. Magnetic evolution in transition metal-doped Co3−xMxO4 (M = Ni, Fe, Mg and Zn) nanostructures. Appl. Phys. A 2016, 122, 177. [Google Scholar] [CrossRef]
- Hu, Y.; Ji, C.; Wang, X.; Huo, J.; Liu, Q.; Song, Y. The structural, magnetic and optical properties of TMn@(ZnO)42 (TM = Fe, Co and Ni) hetero-nanostructure. Sci. Rep. 2017, 7, 16485. [Google Scholar] [CrossRef] [PubMed]
- Jawoor, S.S.; Patil, S.A.; Kumbar, M.; Ramawadgi, P.B. Green synthesis of nano sized transition metal complexes containing heterocyclic Schiff base: Structural and morphology characterization and bioactivity study. J. Mol. Struct. 2018, 1164, 378–385. [Google Scholar] [CrossRef]
- Azam, A.; Ahmed, A.S.; Oves, M.; Khan, M.S.; Habib, S.S.; Memic, A. Antimicrobial activity of metal oxide nanoparticles against Gram-positive and Gram-negative bacteria: A comparative study. Int. J. Nanomed. 2012, 7, 6003–6009. [Google Scholar] [CrossRef] [PubMed]
- Atarod, M.; Nasrollahzadeh, M.; Sajadi, S.M. Green synthesis of a Cu/reduced graphene oxide/Fe3O4 nanocomposite using Euphorbia wallichii leaf extract and its application as a recyclable and heterogeneous catalyst for the reduction of 4-nitrophenol and rhodamine B. RSC Adv. 2015, 5, 91532–91543. [Google Scholar] [CrossRef]
- Nasrollahzadeh, M.; Maham, M.; Sajadi, S.M. Green synthesis of CuO nanoparticles by aqueous extract of Gundelia tournefortii and evaluation of their catalytic activity for the synthesis of N -monosubstituted ureas and reduction of 4-nitrophenol. J. Colloid Interface Sci. 2015, 455, 245–253. [Google Scholar] [CrossRef]
- Li, Y.; Liang, J.; Tao, Z.; Chen, J. CuO particles and plates: Synthesis and gas-sensor application. Mater. Res. Bull. 2008, 43, 2380–2385. [Google Scholar] [CrossRef]
- Yuhas, B.D.; Yang, P. Nanowire-Based All-Oxide Solar Cells. J. Am. Chem. Soc. 2009, 131, 3756–3761. [Google Scholar] [CrossRef]
- Lee, B.H.; Ng, M.Z.; Zinn, A.A.; Gan, C.L. Application of copper nanoparticles as die attachment for high power LED. In Proceedings of the 2015 IEEE 17th Electronics Packaging and Technology Conference (EPTC), Singapore, 2–4 December 2015; pp. 1–5. [Google Scholar] [CrossRef]
- Luechinger, N.A.; Athanassiou, E.K.; Stark, W.J. Graphene-stabilized copper nanoparticles as an air-stable substitute for silver and gold in low-cost ink-jet printable electronics. Nanotechnology 2008, 19, 445201. [Google Scholar] [CrossRef]
- Dong, H.; Meininger, A.; Jiang, H.; Moon, K.-S.; Wong, C.P. Magnetic Nanocomposite for Potential Ultrahigh Frequency Microelectronic Application. J. Electron. Mater. 2007, 36, 593–597. [Google Scholar] [CrossRef]
- Iravani, S.; Varma, R.S. Sustainable synthesis of cobalt and cobalt oxide nanoparticles and their catalytic and biomedical applications. Green Chem. 2020, 22, 2643–2661. [Google Scholar] [CrossRef]
- Pourmadadi, M.; Holghoomi, R.; Shamsabadipour, A.; Maleki-Baladi, R.; Rahdar, A.; Pandey, S. Copper nanoparticles from chemical, physical, and green synthesis to medicinal application: A review. Plant Nano Biol. 2024, 8, 100070. [Google Scholar] [CrossRef]
- Gebreslassie, Y.T.; Gebremeskel, F.G. Green and cost-effective biofabrication of copper oxide nanoparticles: Exploring antimicrobial and anticancer applications. Biotechnol. Rep. 2024, 41, e00828. [Google Scholar] [CrossRef] [PubMed]
- López-Moreno, M.L.; Avilés, L.L.; Pérez, N.G.; Irizarry, B.Á.; Perales, O.; Cedeno-Mattei, Y.; Román, F. Effect of cobalt ferrite (CoFe2O4) nanoparticles on the growth and development of Lycopersicon lycopersicum (tomato plants). Sci. Total. Environ. 2016, 550, 45–52. [Google Scholar] [CrossRef] [PubMed]
- Sharma, P.; Sharma, A.; Sharma, M.; Bhalla, N.; Estrela, P.; Jain, A.; Thakur, P.; Thakur, A. Nanomaterial Fungicides: In Vitro and In Vivo Antimycotic Activity of Cobalt and Nickel Nanoferrites on Phytopathogenic Fungi. Glob. Challenges 2017, 1, 1700041. [Google Scholar] [CrossRef]
- Ogunyemi, S.O.; Xu, X.; Xu, L.; Abdallah, Y.; Rizwan, M.; Lv, L.; Ahmed, T.; Ali, H.M.; Khan, F.; Yan, C.; et al. Cobalt oxide nanoparticles: An effective growth promoter of Arabidopsis plants and nano-pesticide against bacterial leaf blight pathogen in rice. Ecotoxicol. Environ. Saf. 2023, 257, 114935. [Google Scholar] [CrossRef]
- Shaikh, A.J.; Rasheed, R.; Tahir, M.B.; Bakhat, H.F.; Rafique, M.S.; Rabbani, F. A Review on Synthesis, Characterization and Applications of Copper Nanoparticles Using Green Method. Nano 2017, 12, 1750043. [Google Scholar] [CrossRef]
- Gahlawat, G.; Choudhury, A.R. A review on the biosynthesis of metal and metal salt nanoparticles by microbes. RSC Adv. 2019, 9, 12944–12967. [Google Scholar] [CrossRef]
- Saleh, T.A. Nanomaterials: Classification, properties, and environmental toxicities. Environ. Technol. Innov. 2020, 20, 101067. [Google Scholar] [CrossRef]
- Devadoss, D.; Asirvatham, A.; Kujur, A.; Saaron, G.; Devi, N.; Mary, S.J. Green synthesis of copper oxide nanoparticles from Murraya koenigii and its corrosion resistivity on Ti-6Al-4V dental alloy. J. Mech. Behav. Biomed. Mater. 2023, 146, 106080. [Google Scholar] [CrossRef]
- Nyabadza, A.; McCarthy, É.; Makhesana, M.; Heidarinassab, S.; Plouze, A.; Vazquez, M.; Brabazon, D. A review of physical, chemical and biological synthesis methods of bimetallic nanoparticles and applications in sensing, water treatment, biomedicine, catalysis and hydrogen storage. Adv. Colloid Interface Sci. 2023, 321, 103010. [Google Scholar] [CrossRef]
- Sánchez, D.B.; Hubenthal, F.; Träger, F. Shaping nanoparticles with laser light: A multi-step approach to produce nanoparticle ensembles with narrow shape and size distributions. J. Phys. Conf. Ser. 2007, 59, 240–244. [Google Scholar] [CrossRef]
- Kumar, P.; Krishna, M.G. A comparative study of laser- and electric-field-induced effects on the crystallinity, surface morphology and plasmon resonance of indium and gold thin films. Phys. Status Solidi (a) 2010, 207, 947–954. [Google Scholar] [CrossRef]
- Mescola, A.; Canale, C.; Fragouli, D.; Athanassiou, A. Controlled formation of gold nanostructures on biopolymer films upon electromagnetic radiation. Nanotechnology 2017, 28, 415601. [Google Scholar] [CrossRef] [PubMed]
- Balu, S.K.; Andra, S.; Jeevanandam, J.; Kulabhusan, P.K.; Khamari, A.; Vedarathinam, V.; Hamimed, S.; Chan, Y.S.; Danquah, M.K. Exploring the potential of metal oxide nanoparticles as fungicides and plant nutrient boosters. Crop. Prot. 2023, 174, 106398. [Google Scholar] [CrossRef]
- Guzmán Barba, T.; Estrada Flores, M.; Rojas Valencia, O.G.; Manríquez Ramírez, M.E.; Reza San Germán, C.M. Síntesis Mediante la Técnica Solvotermal de Partículas Nanoestructuradas de WO3 Dopadas con S Palabras Clave; Universidad Autónoma Metropolina: Mexico City, Mexico, 2019. [Google Scholar]
- Lai, J.; Niu, W.; Luque, R.; Xu, G. Solvothermal synthesis of metal nanocrystals and their applications. Nano Today 2015, 10, 240–267. [Google Scholar] [CrossRef]
- Satyavani, T.; Kumar, A.S.; Rao, P.S. Methods of synthesis and performance improvement of lithium iron phosphate for high rate Li-ion batteries: A review. Eng. Sci. Technol. Int. J. 2016, 19, 178–188. [Google Scholar] [CrossRef]
- Wen, S.; Bao, G.; Jin, D. Advanced optical properties of upconversion nanoparticles. In Encyclopedia of Nano-Materials, 1st ed.; Yin, Y., Lu, Y., Xia, Y., Eds.; Elsevier: Oxford, UK, 2023; pp. 613–648. [Google Scholar] [CrossRef]
- Chatterjee, S.; Mahanty, S.; Das, P.; Chaudhuri, P.; Das, S. Biofabrication of iron oxide nanoparticles using manglicolous fungus Aspergillus niger BSC-1 and removal of Cr(VI) from aqueous solution. Chem. Eng. J. 2020, 385, 123790. [Google Scholar] [CrossRef]
- Nath, D.; Banerjee, P. Green nanotechnology—A new hope for medical biology. Environ. Toxicol. Pharmacol. 2013, 36, 997–1014. [Google Scholar] [CrossRef]
- Shedbalkar, U.; Singh, R.; Wadhwani, S.; Gaidhani, S.; Chopade, B. Microbial synthesis of gold nanoparticles: Current status and future prospects. Adv. Colloid Interface Sci. 2014, 209, 40–48. [Google Scholar] [CrossRef]
- Tesfaye, M.; Gonfa, Y.; Tadesse, G.; Temesgen, T.; Periyasamy, S. Green synthesis of silver nanoparticles using Vernonia amygdalina plant extract and its antimicrobial activities. Heliyon 2023, 9, e17356. [Google Scholar] [CrossRef]
- Dousari, A.S.; Hosseininasab, S.S.; Akbarizadeh, M.R.; Naderifar, M.; Satarzadeh, N. Mentha pulegium as a source of green synthesis of nanoparticles with antibacterial, antifungal, anticancer, and antioxidant applications. Sci. Hortic. 2023, 320, 112215. [Google Scholar] [CrossRef]
- Iliger, K.S.; Sofi, T.A.; Bhat, N.A.; Ahanger, F.A.; Sekhar, J.C.; Elhendi, A.Z.; Al-Huqail, A.A.; Khan, F. Copper nanoparticles: Green synthesis and managing fruit rot disease of chilli caused by Colletotrichum capsici. Saudi J. Biol. Sci. 2021, 28, 1477–1486. [Google Scholar] [CrossRef]
- Vinayagam, R.; Hebbar, A.; Kumar, P.S.; Rangasamy, G.; Varadavenkatesan, T.; Murugesan, G.; Srivastava, S.; Goveas, L.C.; Kumar, N.M.; Selvaraj, R. Green synthesized cobalt oxide nanoparticles with photocatalytic activity towards dye removal. Environ. Res. 2023, 216, 114766. [Google Scholar] [CrossRef] [PubMed]
- Pariona, N.; Mtz-Enriquez, A.I.; Sánchez-Rangel, D.; Carrión, G.; Paraguay-Delgado, F.; Rosas-Saito, G. Green-synthesized copper nanoparticles as a potential antifungal against plant pathogens. RSC Adv. 2019, 9, 18835–18843. [Google Scholar] [CrossRef] [PubMed]
- Zare-Bidaki, M.; Aramjoo, H.; Mizwari, Z.M.; Mohammadparast-Tabas, P.; Javanshir, R.; Mortazavi-Derazkola, S. Cytotoxicity, antifungal, antioxidant, antibacterial and photodegradation potential of silver nanoparticles mediated via Medicago sativa extract. Arab. J. Chem. 2022, 15, 103842. [Google Scholar] [CrossRef]
- Król, A.; Railean-Plugaru, V.; Pomastowski, P.; Buszewski, B. Phytochemical investigation of Medicago sativa L. extract and its potential as a safe source for the synthesis of ZnO nanoparticles: The proposed mechanism of formation and antimicrobial activity. Phytochem. Lett. 2019, 31, 170–180. [Google Scholar] [CrossRef]
- Mulu, M.; RamaDevi, D.; Belachew, N.; Basavaiah, K. Hydrothermal green synthesis of MoS2 nanosheets for pollution abatement and antifungal applications. RSC Adv. 2021, 11, 24536–24542. [Google Scholar] [CrossRef]
- Ocsoy, I.; Demirbas, A.; McLamore, E.S.; Altinsoy, B.; Ildiz, N.; Baldemir, A. Green synthesis with incorporated hydrothermal approaches for silver nanoparticles formation and enhanced antimicrobial activity against bacterial and fungal pathogens. J. Mol. Liq. 2017, 238, 263–269. [Google Scholar] [CrossRef]
- Yaghoobi, M.; Asjadi, F.; Sanikhani, M. A facile one-step green hydrothermal synthesis of paramagnetic Fe3O4 nanoparticles with highly efficient dye removal. J. Taiwan Inst. Chem. Eng. 2023, 144, 104774. [Google Scholar] [CrossRef]
- Tiwari, A.D.; Mishra, A.K.; Mishra, S.B.; Kuvarega, A.T.; Mamba, B.B. Stabilisation of silver and copper nanoparticles in a chemically modified chitosan matrix. Carbohydr. Polym. 2013, 92, 1402–1407. [Google Scholar] [CrossRef]
- de Godoi, F.C.; Rabelo, R.B.; Silva, M.A.; Rodríguez-Castellón, E.; Guibal, E.; Beppu, M.M. Introduction of copper nanoparticles in chitosan matrix as strategy to enhance chromate adsorption. Chem. Eng. Process.-Process. Intensif. 2014, 83, 43–48. [Google Scholar] [CrossRef]
- Lincoln, S.; Chowdhury, P.; Posen, P.E.; Robin, R.; Ramachandran, P.; Ajith, N.; Harrod, O.; Hoehn, D.; Harrod, R.; Townhill, B.L. Interaction of climate change and marine pollution in Southern India: Implications for coastal zone management practices and policies. Sci. Total. Environ. 2023, 902, 166061. [Google Scholar] [CrossRef] [PubMed]
- Bebber, D.P. Climate change effects on Black Sigatoka disease of banana. Philos. Trans. R. Soc. B Biol. Sci. 2019, 374, 20180269. [Google Scholar] [CrossRef]
- de C. Exterior, M. Informe Sector Bananero. 2017. Available online: https://www.produccion.gob.ec/wp-content/uploads/2019/06/Informe-sector-bananero-espa%C3%B1ol-04dic17.pdf (accessed on 11 December 2023).
- Álvarez, S.P.; López, N.E.L.; Lozano, J.M.; Negrete, E.A.R.; Cervantes, M.E.S. Plant Fungal Disease Manage-ment Using Nanobiotechnology as a Tool. In Advances and Applications Through Fungal Nanobiotechnology; Prasad, R., Ed.; in sobre biología de hongos; Springer International Publishing: Cham, Switzerland, 2016; pp. 169–192. [Google Scholar] [CrossRef]
- Marcia, H.; Sánchez, G.; Aguilar, E.E.J.; Noemi, S.; Reyes, H.; Aguilar, J. Fungicides based on sulfur and bacillus sp. in integrated ma-nagement of black sigatoka. Rev. Científica Agroecosistemas 2022, 3, 153–158. [Google Scholar]
- Cerna-Chávez, E.; Malacara-Herrera, I.D.R.; Ochoa-Fuentes, Y.M.; Hernández-Juárez, A. Evaluación in vitro de extractos vegetales adicionados con nanopartículas para el control de Fusarium oxysporum. Ecosistemas Recur. Agropecu. 2023, 10. [Google Scholar] [CrossRef]
- Jindal, K. Synthesis, Characterization and Evaluation of Antifungal activity of Copper Nanoparticle. 2023. Available online: https://krishikosh.egranth.ac.in/handle/1/5810209194 (accessed on 14 November 2024).
- Vera-Reyes, I.; Altamirano-Hernández, J.; la Cruz, H.R.-D.; Granados-Echegoyen, C.A.; Loera-Alvarado, G.; López-López, A.; Garcia-Cerda, L.A.; Loera-Alvarado, E. Inhibition of Phytopathogenic and Beneficial Fungi Applying Silver Nanoparticles In Vitro. Molecules 2022, 27, 8147. [Google Scholar] [CrossRef] [PubMed]
- Song, K.; Zhao, D.; Sun, H.; Gao, J.; Li, S.; Hu, T.; He, X. Green nanopriming: Responses of alfalfa (Medicago sativa L.) seedlings to alfalfa extracts capped and light-induced silver nanoparticles. BMC Plant Biol. 2022, 22, 323. [Google Scholar] [CrossRef]
- Marslin, G.; Siram, K.; Maqbool, Q.; Selvakesavan, R.K.; Kruszka, D.; Kachlicki, P.; Franklin, G. Secondary Metabolites in the Green Synthesis of Metallic Nanoparticles. Materials 2018, 11, 940. [Google Scholar] [CrossRef]
- Patle, T.K.; Shrivas, K.; Kurrey, R.; Upadhyay, S.; Jangde, R.; Chauhan, R. Phytochemical screening and determination of phenolics and flavonoids in Dillenia pentagyna using UV–vis and FTIR spectroscopy. Spectrochim. Acta. A. Mol. Biomol. Spectrosc. 2020, 242, 118717. [Google Scholar] [CrossRef]
- Alhakmani, F.; Alam Khan, S.; Ahmad, A. Determination of total phenol, in-vitro antioxidant and anti-inflammatory activity of seeds and fruits of Zizyphus spina-christi grown in Oman. Asian Pac. J. Trop. Biomed. 2014, 4, S656–S660. [Google Scholar] [CrossRef]
- Caunii, A.; Pribac, G.; Grozea, I.; Gaitin, D.; Samfira, I. Design of optimal solvent for extraction of bio–active ingredients from six varieties of Medicago sativa. BMC Chem. 2012, 6, 123. [Google Scholar] [CrossRef] [PubMed]
- Khalaji, A.D.; Pazhand, Z.; Kiani, K.; Machek, P.; Jarosova, M.; Mazandarani, R. CuO nanoparticles: Preparation, characterization, optical properties, and antibacterial activities. J. Mater. Sci. Mater. Electron. 2020, 31, 11949–11954. [Google Scholar] [CrossRef]
- Jayarambabu, N.; Akshaykranth, A.; Rao, T.V.; Rao, K.V.; Kumar, R.R. Green synthesis of Cu nanoparticles using Curcuma longa extract and their application in antimicrobial activity. Mater. Lett. 2020, 259, 126813. [Google Scholar] [CrossRef]
- Farhadi, S.; Javanmard, M.; Nadri, G. Characterization of Cobalt Oxide Nanoparticles Prepared by the Thermal Decomposition of [Co(NH3)5(H2O)](NO3)3 Complex and Study of Their Photocatalytic Activity. Acta Chim. Slov. 2016, 63, 335–343. [Google Scholar] [CrossRef] [PubMed]
- Rónavári, A.; Igaz, N.; Adamecz, D.I.; Szerencsés, B.; Molnar, C.; Kónya, Z.; Pfeiffer, I.; Kiricsi, M. Green Silver and Gold Nanoparticles: Biological Synthesis Approaches and Potentials for Biomedical Applications. Molecules 2021, 26, 844. [Google Scholar] [CrossRef] [PubMed]
- Cristiano, E.; Hu, Y.-J.; Sigfried, M.; Kaplan, D.; Nitsche, H. A Comparison of Point of Zero Charge Measurement Methodology. Clays Clay Miner. 2011, 59, 107–115. [Google Scholar] [CrossRef]
- Kosmulski, M. The pH dependent surface charging and points of zero charge. VII. Update. Adv. Colloid Interface Sci. 2018, 251, 115–138. [Google Scholar] [CrossRef] [PubMed]
- Mostafazade, R.; Arabi, L.; Tazik, Z.; Akaberi, M.; Bazzaz, B.S.F. Green synthesis of gold, copper, zinc, iron, and other metal nanoparticles by fungal endophytes; characterization, and their biological activity: A review. Biocatal. Agric. Biotechnol. 2024, 60, 103307. [Google Scholar] [CrossRef]
- Ramakrishnan, V.M.; Li, J.; Wu, Q.; Wu, J. Synthesis of Nanoparticles via Solvothermal and Hydrothermal Methods. In Handbook of Nanoparticles; Aliofkhazraei, M., Ed.; Springer International Publishing: Cham, Switzerland, 2015; pp. 1–28. [Google Scholar]
- Castañeda, M.T. Enzimas de Interés Biotecnológico. 2019. Available online: http://sedici.unlp.edu.ar/handle/10915/89649 (accessed on 28 October 2023).
- Mullaivendhan, J.; Akbar, I.; Ahamed, A.; Alodaini, H.A. Synthesis rifaximin with copper (Rif-Cu) and copper oxide (Rif-CuO) nanoparticles Considerable dye decolorization: An application of aerobic oxidation of eco-friendly sustainable approach. Heliyon 2024, 10, e25285. [Google Scholar] [CrossRef]
- Kayani, Z.N.; Umer, M.; Riaz, S.; Naseem, S. Characterization of Copper Oxide Nanoparticles Fabricated by the Sol–Gel Method. J. Electron. Mater. 2015, 44, 3704–3709. [Google Scholar] [CrossRef]
- Sahai, A.; Goswami, N.; Kaushik, S.; Tripathi, S. Cu/Cu2O/CuO nanoparticles: Novel synthesis by exploding wire technique and extensive characterization. Appl. Surf. Sci. 2016, 390, 974–983. [Google Scholar] [CrossRef]
- Swarnkar, R.K.; Singh, S.C.; Gopal, R. Effect of aging on copper nanoparticles synthesized by pulsed laser ablation in water: Structural and optical characterizations. Bull. Mater. Sci. 2011, 34, 1363–1369. [Google Scholar] [CrossRef]
- Khulbe, R.; Kumar, R.; Kumar, V.; Kandpal, A.; Joshi, R.; Chandra, B.; Kandpal, N.D. Synthesis and Characterization of Copper Oxide Nanoparticles Using Polyol and Their Antimicrobial Potential. Mater. Int. 2024, 6, 2. [Google Scholar] [CrossRef]
- Nagar, N.; Devra, V. Green synthesis and characterization of copper nanoparticles using Azadirachta indica leaves. Mater. Chem. Phys. 2018, 213, 44–51. [Google Scholar] [CrossRef]
- Hassanien, R.; Husein, D.Z.; Al-Hakkani, M.F. Biosynthesis of copper nanoparticles using aqueous Tilia extract: Antimicrobial and anticancer activities. Heliyon 2018, 4, e01077. [Google Scholar] [CrossRef]
- Hutamaningtyas, E.; Utari; Suharyana; Wijayanta, A.T.; Purnama, B. FTIR and structural properties of co-precipitated cobalt ferrite nano particles. J. Phys. Conf. Ser. 2016, 776, 012023. [Google Scholar] [CrossRef]
- Arora, S.; Singla, M.L.; Kapoor, P. Evidence for monoalkoxide species on the surface of palladium nanoparticles synthesized in ethylene glycol. Mater. Chem. Phys. 2009, 114, 107–112. [Google Scholar] [CrossRef]
- Slavov, D.; Tomaszewska, E.; Grobelny, J.; Drenchev, N.; Karashanova, D.; Peshev, Z.; Bliznakova, I. FTIR spectroscopy revealed nonplanar conformers, chain order, and packaging density in diOctadecylamine- and octadecylamine-passivated gold nanoparticles. J. Mol. Struct. 2024, 1314, 138827. [Google Scholar] [CrossRef]
- Nallusamy, S.; Sujatha, K. Experimental analysis of nanoparticles with cobalt oxide synthesized by coprecipitation method on electrochemical biosensor using FTIR and TEM. Mater. Today Proc. 2021, 37, 728–732. [Google Scholar] [CrossRef]
- Maldonado-Lara, K.; Luna-Bárcenas, G.; Luna-Hernández, E.; Padilla-Vaca, F.; Hernández-Sánchez, E.; Betancourt-Galindo, R.; Menchaca-Arredondo, J.L.; España-Sánchez, B.L. Preparación y Caracterización de Nanocompositos Quitosano-Cobre con Actividad Antibacteriana para aplicaciones en Ingeniería de Tejidos. Rev. Mex. Ing. Bioméd. 2017, 38, 306–313. [Google Scholar] [CrossRef]
- Silva, A.O.; Cunha, R.S.; Hotza, D.; Machado, R.A.F. Chitosan as a matrix of nanocomposites: A review on nanostructures, processes, properties, and applications. Carbohydr. Polym. 2021, 272, 118472. [Google Scholar] [CrossRef] [PubMed]
- Lamarra, J.; Giannuzzi, L.; Rivero, S.; Pinotti, A. Assembly of chitosan support matrix with gallic acid-functionalized nanoparticles. Mater. Sci. Eng. C 2017, 79, 848–859. [Google Scholar] [CrossRef] [PubMed]
- Lopez-Lima, D.; Mtz-Enriquez, A.I.; Carrión, G.; Basurto-Cereceda, S.; Pariona, N. The bifunctional role of copper nanoparticles in tomato: Effective treatment for Fusarium wilt and plant growth promoter. Sci. Hortic. 2021, 277, 109810. [Google Scholar] [CrossRef]
- Barros, J.; Kumar, S.; Seena, S. Does functionalised nanoplastics modulate the cellular and physiological responses of aquatic fungi to metals? Environ. Pollut. 2023, 337, 122549. [Google Scholar] [CrossRef]
- Wang, L.; Hu, C.; Shao, L. The antimicrobial activity of nanoparticles: Present situation and prospects for the future. Int. J. Nanomed. 2017, 12, 1227–1249. [Google Scholar] [CrossRef]

















| Control Plate | Cu-NPs | Co-NPs | |
|---|---|---|---|
| True color image (RGB) | ![]() | ![]() | ![]() |
| False color image (8 bits) | ![]() | ![]() | ![]() |
| Control Plate | Cu-NPs | Co-NPs | |
|---|---|---|---|
| True color image (RGB) | ![]() | ![]() | ![]() |
| False color image (8 bits) | ![]() | ![]() | ![]() |
Disclaimer/Publisher’s Note: The statements, opinions and data contained in all publications are solely those of the individual author(s) and contributor(s) and not of MDPI and/or the editor(s). MDPI and/or the editor(s) disclaim responsibility for any injury to people or property resulting from any ideas, methods, instructions or products referred to in the content. |
© 2025 by the authors. Licensee MDPI, Basel, Switzerland. This article is an open access article distributed under the terms and conditions of the Creative Commons Attribution (CC BY) license (https://creativecommons.org/licenses/by/4.0/).
Share and Cite
Caguana, T.; Cruzat, C.; Herrera, D.; Peña, D.; Arévalo, V.; Vera, M.; Chong, P.; Novoa, N.; Arrué, R.; Vanegas, E. Metal Nanoparticles Obtained by Green Hydrothermal and Solvothermal Synthesis: Characterization, Biopolymer Incorporation, and Antifungal Evaluation Against Pseudocercospora fijiensis. Nanomaterials 2025, 15, 379. https://doi.org/10.3390/nano15050379
Caguana T, Cruzat C, Herrera D, Peña D, Arévalo V, Vera M, Chong P, Novoa N, Arrué R, Vanegas E. Metal Nanoparticles Obtained by Green Hydrothermal and Solvothermal Synthesis: Characterization, Biopolymer Incorporation, and Antifungal Evaluation Against Pseudocercospora fijiensis. Nanomaterials. 2025; 15(5):379. https://doi.org/10.3390/nano15050379
Chicago/Turabian StyleCaguana, Tania, Christian Cruzat, David Herrera, Denisse Peña, Valeria Arévalo, Mayra Vera, Pablo Chong, Néstor Novoa, Ramón Arrué, and Eulalia Vanegas. 2025. "Metal Nanoparticles Obtained by Green Hydrothermal and Solvothermal Synthesis: Characterization, Biopolymer Incorporation, and Antifungal Evaluation Against Pseudocercospora fijiensis" Nanomaterials 15, no. 5: 379. https://doi.org/10.3390/nano15050379
APA StyleCaguana, T., Cruzat, C., Herrera, D., Peña, D., Arévalo, V., Vera, M., Chong, P., Novoa, N., Arrué, R., & Vanegas, E. (2025). Metal Nanoparticles Obtained by Green Hydrothermal and Solvothermal Synthesis: Characterization, Biopolymer Incorporation, and Antifungal Evaluation Against Pseudocercospora fijiensis. Nanomaterials, 15(5), 379. https://doi.org/10.3390/nano15050379